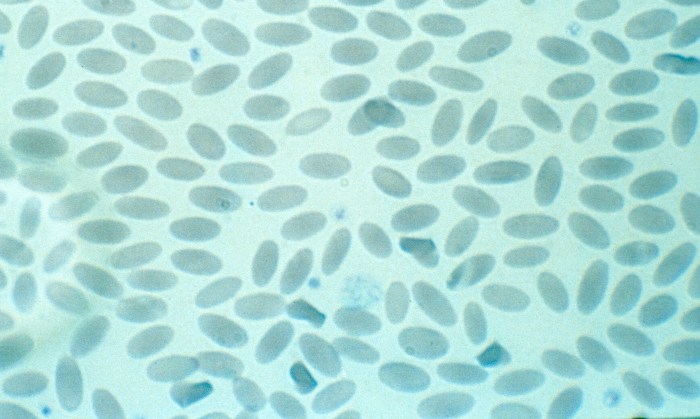
Normal Llama 1
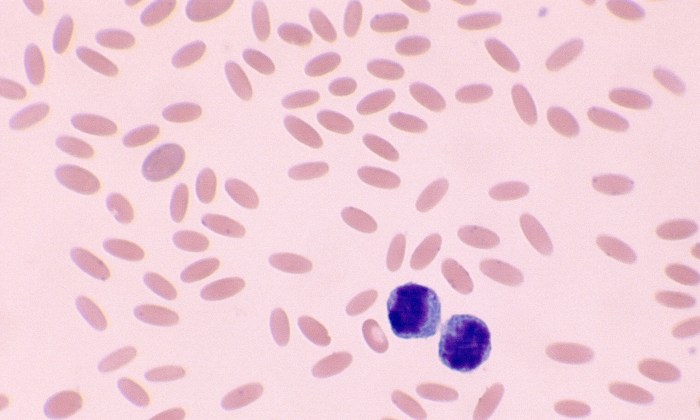
Normal Llama 2

Normal Camelid Erythrocytes

Morphology: llamas, alpacas, and camels have small, flat, oval-shaped red blood cells.
Lifespan: 60 days
Other features: mild anisocytosis and poikilocytosis may be present in healthy llamas. Mean corpuscular hemoglobin concentration (MCHC) in camelids are significantly higher than other species (usually 40-50 g/dL).